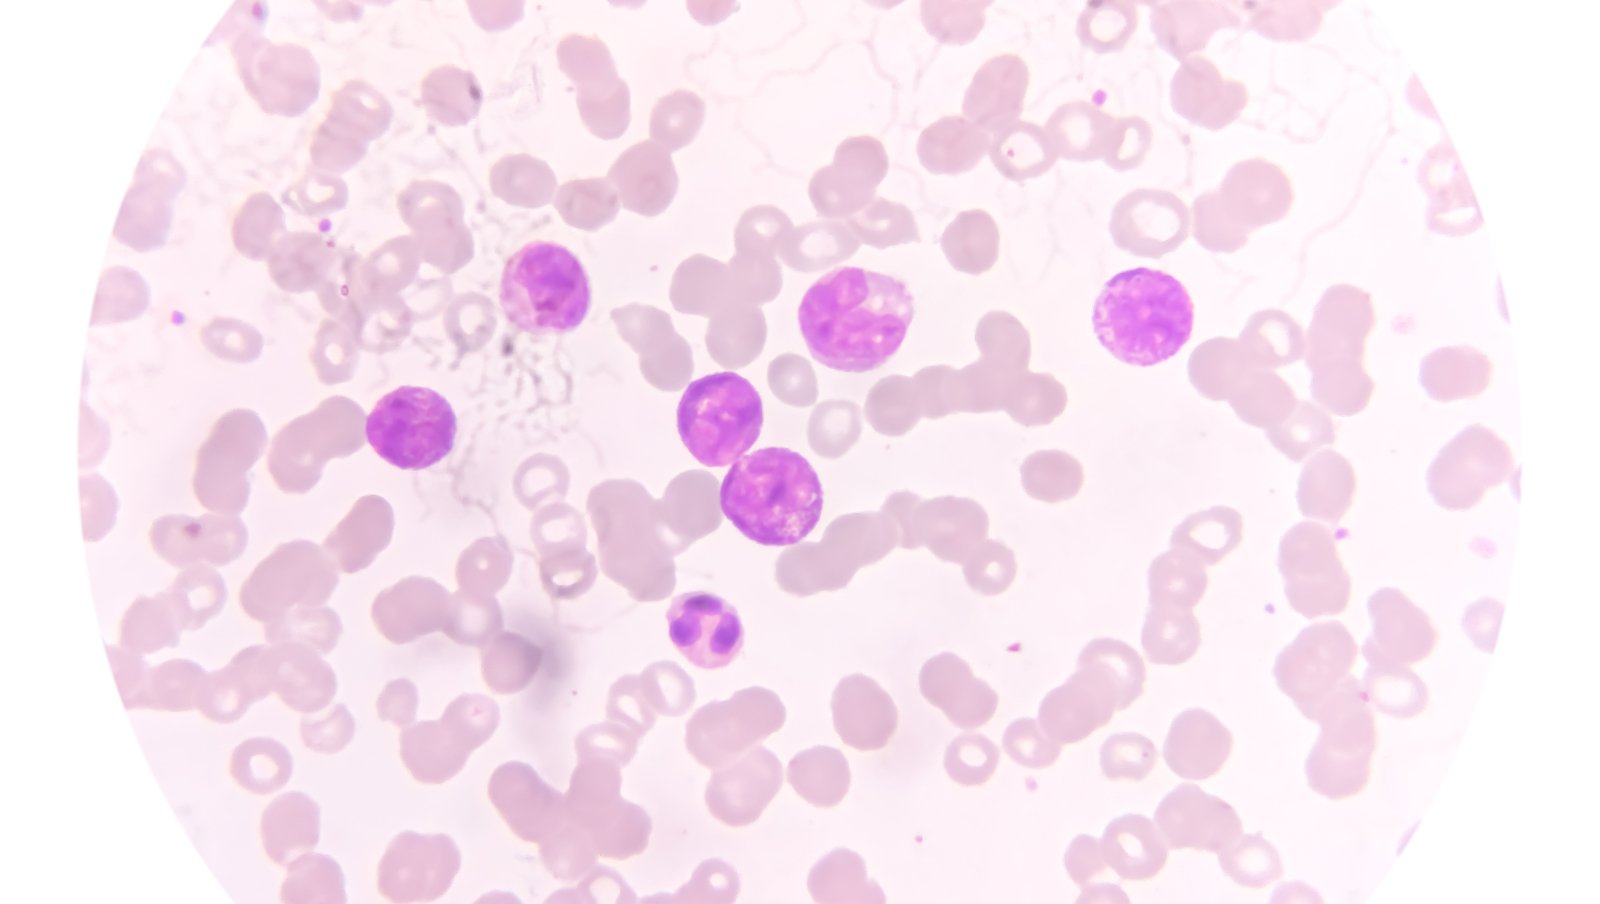
Leczenie ostrej białaczki szpikowej wysokiego ryzyka (t-AML, AML-MRC) w praktyce...

Ostre białaczki

13.03.2023
lek. Aneta Nowicka
Inhibitor meniny w leczeniu AML - nowe cele terapii na ASH 2022

10.01.2023
lek. Aneta Nowicka
FLT3, B-ALL i CAR T - znani aktorzy w nowym scenariuszu

5.01.2023
prof. dr hab. n. med. Piotr Rzepecki
Rola przeszczepu allogenicznego u dorosłych z Ph+ ALL w CR1 z całkowitą remisją molekularną: analiza retrospektywna

3.01.2023
lek. Aneta Nowicka
CAR-T CD19 + CD22 = 99% CR u dzieci z nawrotową lub oporną na leczenie B-ALL

8.12.2022
lek. Marta Masternak
Wenetoklaks wykazuje aktywność w nowo zdiagnozowanej AML

17.11.2022
Hematoonkologia.pl
Zmiany systemowe w dostępie do terapii dla chorych na ostrą białaczkę szpikową

27.10.2022
lek. A. Nowicka
Inhibitory meniny mogą stać się kolejną metodą terapii celowanej w AML

26.10.2022
Hematoonkologia.pl
Prof. Jan Maciej Zaucha o nowej terapii w ostrej białaczce szpikowej

15.09.2022
lek. A. Nowicka
Ostra białaczka szpikowa jako choroba... sezonowa?

8.09.2022
dr n. med. Aleksandra Gołos
Monitorowanie mierzalnej choroby resztkowej

1.09.2022
prof. Joanna Góra-Tybor